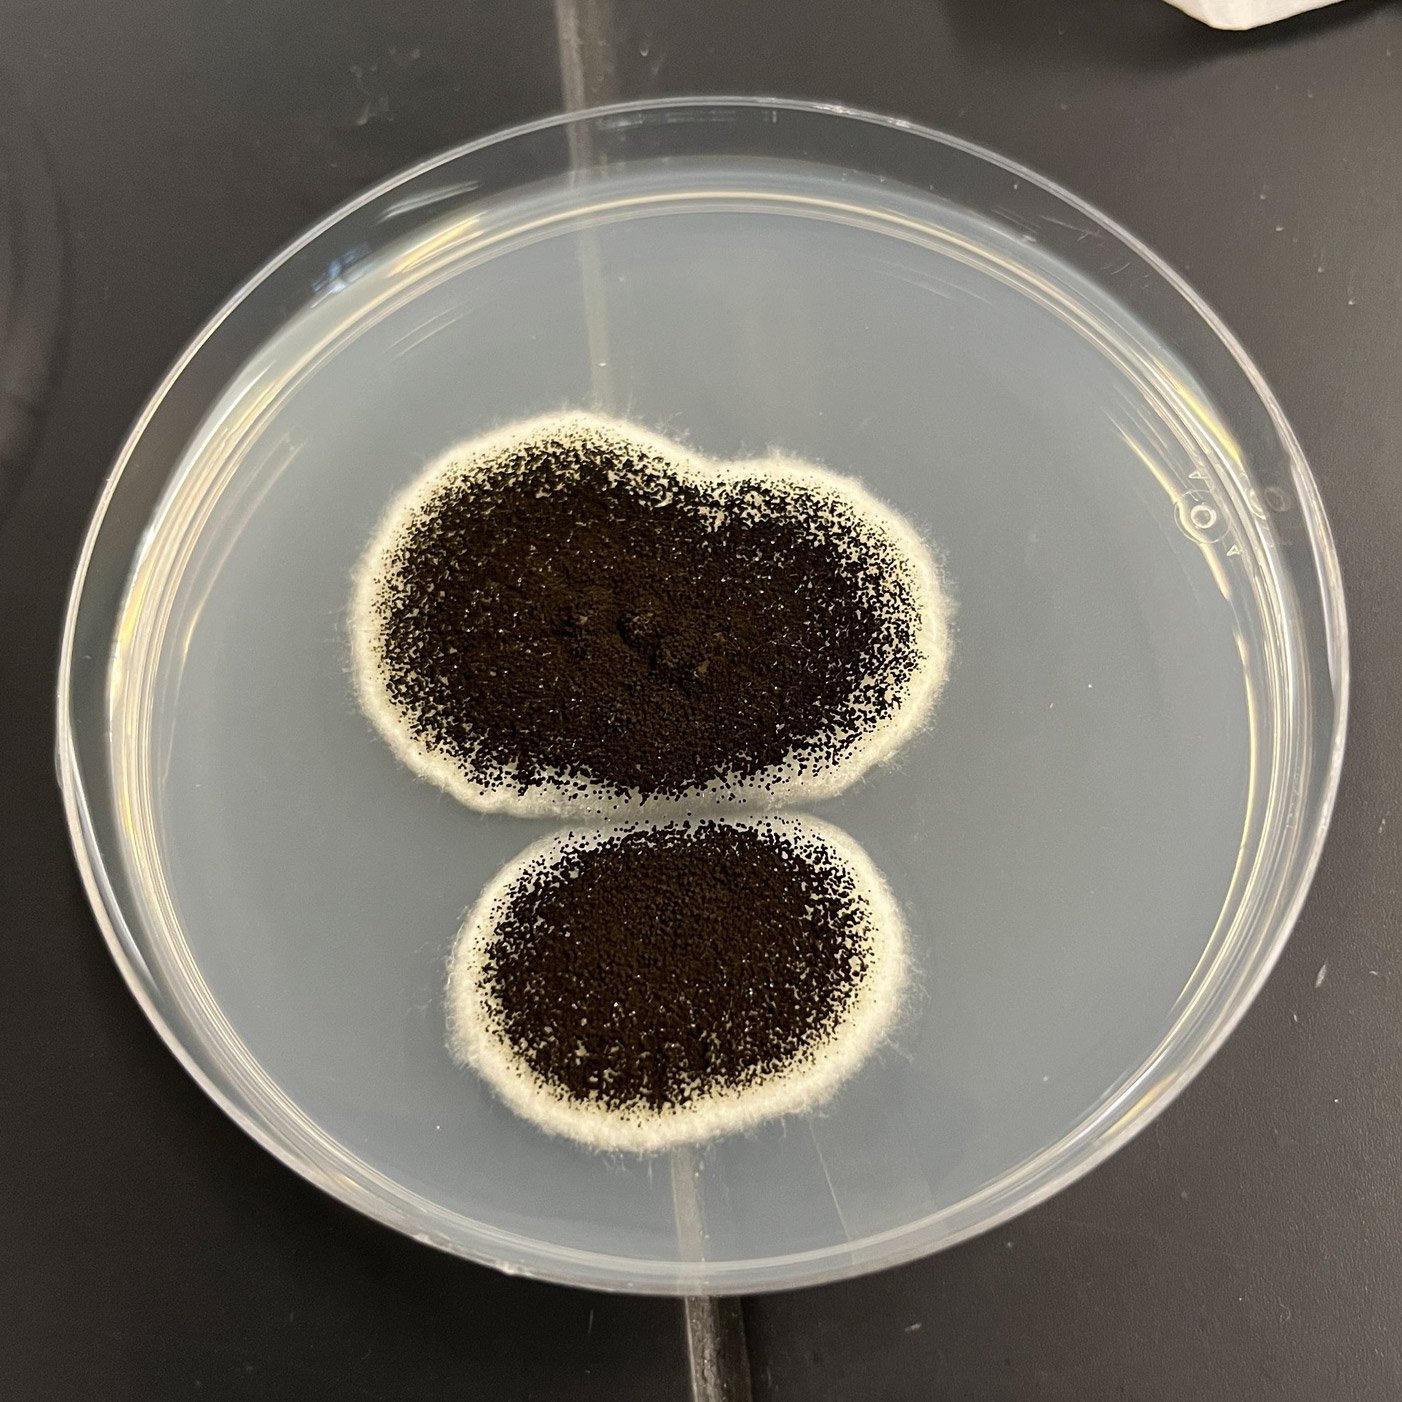
Aspergillus niger culture on a petri dish.

Panic is usually the first symptom of finding a black spot on your wall. But statistically, 70% of “black mold” in American homes is not the toxic variety.
The 70% Rule
Industrial Hygienists estimate that less than 30% of black-colored growth is Stachybotrys chartarum (Toxic Black Mold). The vast majority are “Imposters”—allergenic molds that look scary but are often caused by simple humidity, not structural leaks.
The “Microscope Rule”
Here is the honest truth that most remediation companies won’t tell you: To the naked eye, a harmless colony of Cladosporium can look identical to a toxic colony of Stachybotrys. No human on earth can guarantee the species of a mold just by looking at a photo.
However, Biology Leaves Clues…
While absolute confirmation requires a lab, you can perform a Visual Risk Assessment right now. By analyzing what the mold is eating (the substrate) and where it is growing, we can calculate the statistical probability of it being “Toxic” (Hazard Class A) vs. “Allergenic” (Hazard Class B).
Quick Start: The 30-Second Texture Test
You do not need a microscope to spot the first warning sign. You need a flashlight and a good angle. The texture tells the story.

“Powdery texture indicates Cladosporium or Aspergillus feeding on dust.”
- Texture: Powdery, fuzzy, or velvety.
- Wipe Test: Wipes off like dust.
- Cause: Condensation.

“Thick, heavy growth on wet drywall indicates a long-term cellulose eater.”
- Texture: Slimy, wet, or shiny.
- Wipe Test: Smears like mud.
- Cause: Active Leak.
Imposter #1: Windows & Vents (Condensation)
If you see black spots on your window sills, bathroom ceilings, or painted frames, it is almost certainly Cladosporium.
Variation: The AC Vent
We often see this same mold on HVAC diffusers. The mechanism is the same: cold metal creates condensation, dust sticks to the wet metal, and mold eats the dust.
The Fix: This is usually a ventilation issue, not a remediation issue. Improve airflow and wipe with a botanical cleaner.
Imposter #2: Shower Grout (Pepper Spots)
Often found in showers, this looks like someone sprinkled black pepper on your grout lines or silicone caulk. It is actually the same mold you find on old onions in your pantry.
🔬 Scientific Verification
Unlike toxic black mold (which looks like oval footballs under a microscope), Aspergillus looks like a dandelion. These round heads release spores easily into the air.

Microscopic Structure
Petri Dish Culture
Imposter #3: The “Rubber Ring” (Front Loaders)
If you pull back the rubber seal of your washing machine, you might find a thick, jet-black slime. It looks terrifyingly similar to toxic black mold.
The Fix: Run an empty “Sanitize” cycle with bleach or a dedicated washing machine cleaner tablet.
Imposter #4: The “Tank Terror” (Inside Toilet)
You lift the lid of your toilet tank and see black spotting covering the white porcelain or Styrofoam insulation.
The Fix: Drop a chlorine tablet into the tank (if safe for your plumbing) or scrub with vinegar.
Imposter #5: The “Sweaty Pipe” (Basement/PVC)
Black spotting on white PVC drainage pipes or copper lines, usually found in basements or crawlspaces.
The Fix: Wipe down the pipes and insulate them to stop the sweating.
Rapid Identification Matrix
Use this logic gate to decide your next step.
| Location | Appearance | Likely Suspect | Action Profile |
|---|---|---|---|
| Window Sill / Glass | Black Spots (Dry) | Cladosporium | Ventilation |
| Shower Grout | Pepper / Grimy | Aspergillus niger | Cleaning |
| Flooded Drywall | Slimy / Shiny Black | Stachybotrys | Evacuate / Pro |
| AC Vent | Fuzzy / Gray | Cladosporium / Dust | HVAC Clean |
It’s “Powdery” or on Windows?
You likely have a humidity problem, not a toxic leak. Stop the growth by controlling the air moisture.
See Recommended DehumidifiersIt’s “Slimy” or on Wet Drywall?
This is a Hazard Class A indicator. Do not disturb the spores. Get a professional inspection immediately.
Find a Verified Inspector






